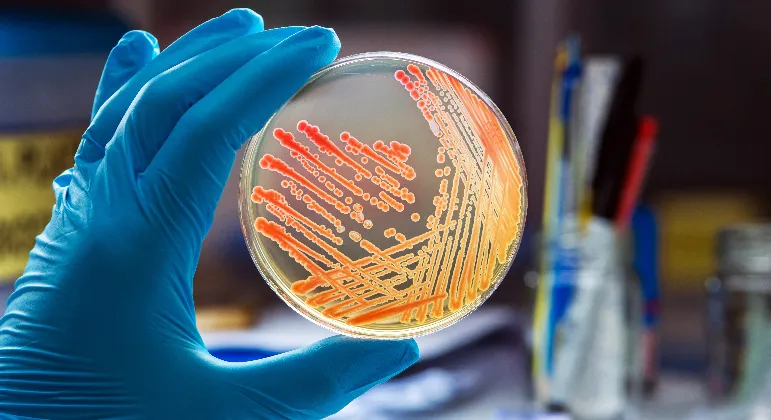
Thumbnail

Tus resultados en
Laboratorio
Laboratorio
Zapata Rio Tijuana
10 años de experiencia resopaldan la calidad y precisión de nuestro laboratorio clínico.
En nuestro laboratorio, la atención personalizada y responsable es crucial. Permite comprender las distintas necesidades únicas de cada paciente, brindar un trato humano y generar confianza. Además, el tener una comunicación óptima nos permite garantizar resultados precisos para favorecer diagnósticos certeros que nos ayudarán a contribuír en el bienestar y la salud de nuestros pacientes.
- Análisis de sangre
- Pruebas de química clínica
- Análisis de orina
- Perfil hormonal
- Pruebas de enfermedades infecciosas
- Pruebas de marcadores tumorales